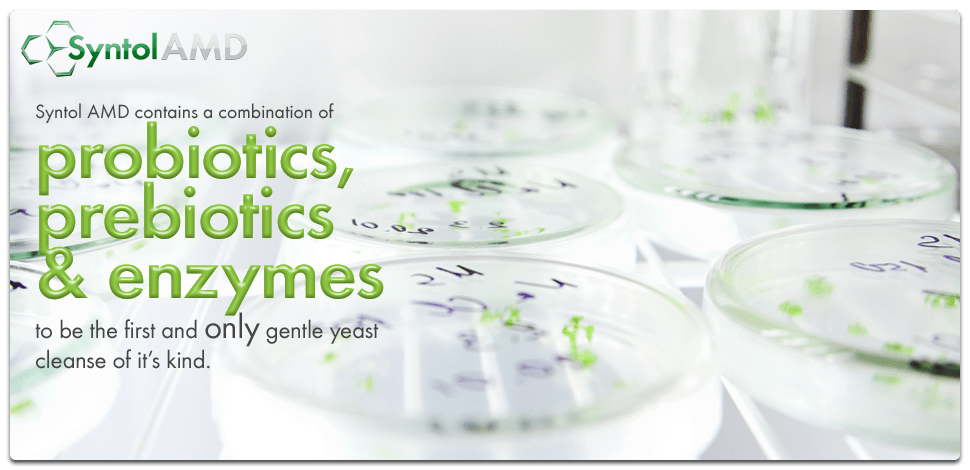
Promotional image for Syntol AMD from Advanced Supplements
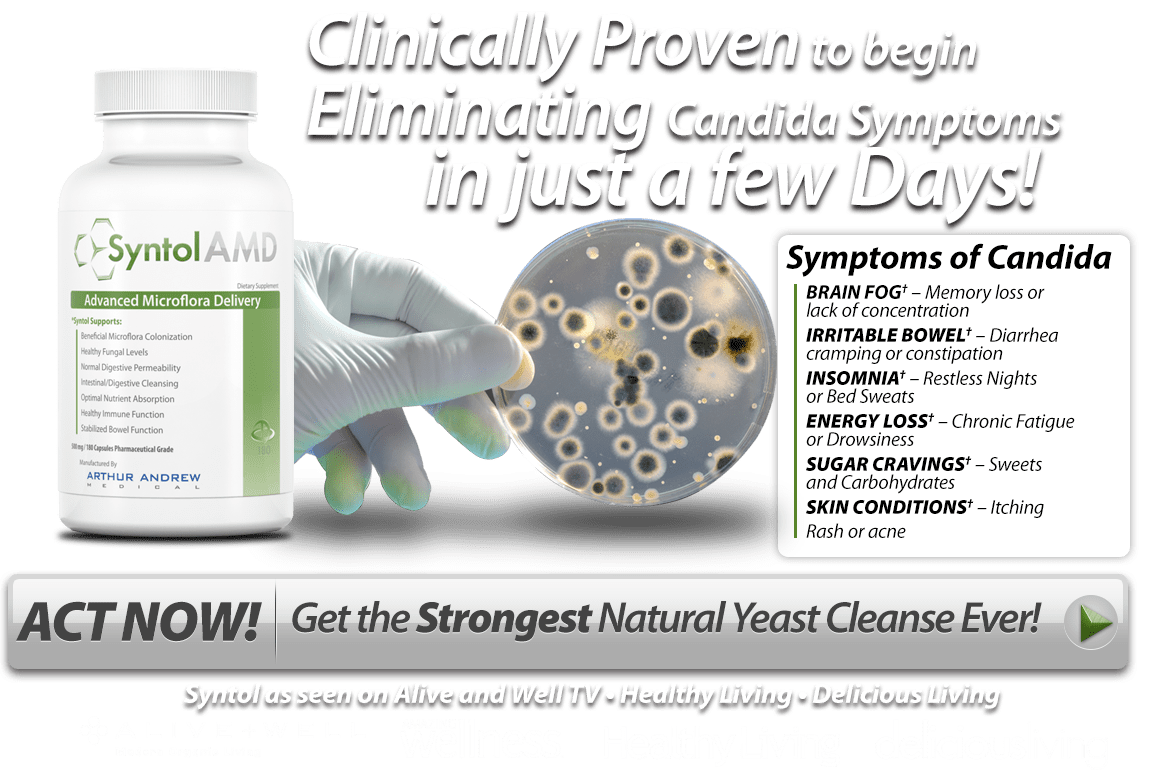
Image showing how Syntol AMD Can eliminate Candida

Syntol AMD – Probiotic Candida Supplement
Price range: £63.00 through £110.00
Syntol is a combination of probiotics and prebiotics more commonly referred to and classified as synbiotics.
- Candida cleanse and prevention
- Eliminates the overgrowth of yeast and bacteria in the gastro-intestinal tract
- Enhances immune response
- Facilitates toxin and pathogen removal
- Helps to prevent infectious diarrohea
- Improves the digestive process and helps to suppress disease causing bacteria
- Increases immune function and bacterial resistance
- Increases intestinal nutrient absorption
- Increases oxygenation of the digestive tract
- Natural antibiotic function
- Prevents or reduces the occurrence of yeast infections
- Proteolytic enzyme ingredients digest and remove yeasts, bacteria and fungal proliferation
- Reduces digestive permeability
- Replaces friendly intestinal bacteria destroyed by antibiotics
Price range: £63.00 through £110.00
Syntol AMD as a Candida Cleanse (Thrush Prevention) Supplement
Syntol AMD is a Symbiotic Formula with Pro-Biotics, Pre-Biotics, Candida Cleanse and Enzymes
- Natural antibiotic function
- Candida cleanse and prevention
- Reduces digestive permeability
- Facilitates toxin and pathogen removal
- Increases immune function and bacterial resistance
- Increases intestinal nutrient absorption
- Increases oxygenation of the digestive tract
Are you struggling with thrush caused by candida overgrowth and looking for a natural solution? Look no further than Syntol AMD! This powerful symbiotic formula combines pro-biotics, pre-biotics, a candida cleanse, and enzymes to support your overall digestive and immune health.
Syntol AMD’s blend of probiotics and prebiotics creates an environment that is inhospitable to yeast colonies and undesirable microorganisms, while its enzyme blend helps to eliminate toxins and harmful bacteria from the body without causing unpleasant side effects. In addition, Syntol AMD supports immune function, increases nutrient absorption, and improves oxygenation in the digestive tract.
But that’s not all – Syntol AMD also includes inulin, a prebiotic derived from chicory root that promotes the growth of probiotics and bifidobacterial in the large intestine. With Syntol AMD, you can cleanse your body of candida and support your overall health and wellness. Don’t wait any longer to try this natural and effective solution for your candida concerns.
Other Syntol Supplement Benefits Include
- Prevents or reduces the occurrence of yeast infections
- Improves the digestive process and helps to suppress disease causing bacteria
- Helps to prevent infectious diarrhoea
- Eliminates the overgrowth of yeast and bacteria in the gastro-intestinal tract
- Replaces friendly intestinal bacteria destroyed by antibiotics
- Proteolytic enzyme ingredients digest and remove yeasts, bacteria and fungal proliferation
- Enhances immune response
How Syntol Supplements Help Prevent Thrush
Probiotic bacteria may help maintain a healthy balance of bacteria and yeast colonies in the intestinal tract, improve digestion, and support a strong immune system. People who have healthy gut colonies of “probiotic” helpful bacteria may be better able to combat an increase of dangerous bacteria. Probiotics compete with yeast and other bacteria for attachment sites along the digestive tract when they are introduced. Intestinal homeostasis can be restored when the healthy bacteria virtually crowd out the bad.
Syntol contains 13.6 billion CFUs (Colony Forming Units) of probiotic bacteria from a variety of non-competing strains. The powerful B. subtilis strain, a spore-forming bacteria, is one of these strains. In less than ideal circumstances, spore germination is a trustworthy method of supplying the intestine with healthy flora. The majority of bacteria are sensitive to all acidic pH levels and thrive mostly in the lower GI, which is more alkaline. However, spores can resist a wider variety of pH and temperature ranges.
This increases the probiotic strain’s likelihood of correctly germination and the onset of the process of re-establishing intestinal equilibrium.
Our researchers focused on researching the enzymes that grow on decomposing yeast in experimental settings. The Syntol recipe was then modified by concentrating and reproducing similar enzymes. Some enzymes are drawn to dying candida cells and break down or digest them.
The breakdown of rotting and dead yeast is facilitated by the enzyme yeast candida cleanse. This helps the body eliminate toxic yeast normally before it has a chance to ferment and generate unfavourable detox symptoms-causing compounds like formaldehyde.
Prebiotics are soluble fibres that promote the development and function of good flora. Isomalto-oligosaccharide is present in Syntol (IMO). IMO is a prebiotic fibre that is 100% resistant to biological digestion and is certified organic. IMO can safely pass past the stomach and into the intestine, where it fosters the growth of probiotics in the best possible conditions. In contrast to other prebiotics like inulin and FOS, IMO has been demonstrated to induce the least number of uncomfortable sensations.
Syntol AMD Supplements For Digestive Support
Syntol is a unique probiotic supplement that contains a blend of 13.6 billion colony forming units (CFUs) of various non-competing strains of beneficial bacteria per dose. These strains have been carefully selected for their ability to work together synergistically to support overall digestive and immune health.
One of the standout strains in Syntol is the spore-forming bacteria B. subtilis. This powerful strain is known for its ability to thrive in less than ideal conditions and has been shown to have immune-supportive properties. In clinical studies, B. subtilis has been shown to be effective at reducing the frequency of gastrointestinal symptoms such as occasional gas, nausea, constipation, and diarrhea. It may also help to maintain a healthy balance of bacteria in the gut microbiome.
In addition to B. subtilis, Syntol also contains a variety of other probiotic strains that have been shown to support digestive health and immune function. These include Lactobacillus acidophilus, Lactobacillus plantarum, and Bacillus coagulans. Together, these strains work to promote a healthy and balanced gut microbiome, which is essential for overall health and well-being.
Overall, Syntol is a unique and effective probiotic supplement that can help to support a healthy digestive system and immune system. Its powerful blend of various probiotic strains, including B. subtilis, makes it an excellent choice for those looking to maintain optimal digestive and immune health.
The Gut Health & Mood Enhancing Benefits Of Syntol
Syntol contains beneficial bacteria that have a number of unique health benefits, particularly when it comes to the gut-brain axis (GBA), the connection between the gut and the brain. One of the key ways in which probiotics can support the GBA is by stimulating the production of tryptophan, an amino acid that is converted into serotonin, a neurotransmitter that plays a role in mood regulation, stress management, and appetite. In fact, probiotics living in our microbiome produce around 95% of our body’s serotonin, which helps to maintain a healthy appetite, sleep pattern, digestion, and overall well-being.
Syntol can also help to restore balance to the microbiome, which is essential for maintaining optimal health. When the microbiome is imbalanced, it can lead to feelings of “hangry,” as well as anxiety, irritability, and other negative mood states. Syntol helps to prevent these negative mood states and may even improve learning, memory, and overall mood. In addition, a diverse microbiome can help to regulate mood between meals and allow people to sustain better mood regulation, even when fasting.
The probiotics found in our blend of Syntol AMD include Lactobacillus acidophilus, Lactobacillus plantarum, and Bacillus coagulans, among others. In addition to these probiotics, Syntol also contains a prebiotic fiber that nourishes good bacteria and promotes their growth, as well as digestive enzymes to ensure that food is thoroughly digested. These enzymes help to break down food properly, which helps to ensure that nutrients are properly absorbed and transported throughout the body, including the brain. By supporting a healthy gut microbiome and improving digestion, Syntol can help to enhance mental health, digestion, and overall quality of life.
How Syntol Candida Cleansing Supplements Are Refined
Spore germination technique, a cutting-edge innovative method used by Syntol AMD, distributes probiotic spores rather than live bacteria. Probiotic spores are latent organisms that shield bacteria from acidic environments as well as extremely high and low temperatures. The probiotic bacteria are created when these spores germinate after adhering to the gut mucosa.
Spore germination technology is a very reliable way to distribute probiotics under less than perfect circumstances. These spores don’t need to be refrigerated or packaged in glass.
Extremely anoxic (non-oxygenated) environments are ideal for yeast growth. A highly oxygenated atmosphere made possible by synthol inhibits the development and spread of yeast colonies. Additionally, by eradicating candida yeasts that have attached themselves to the digestive tract, Synto is a very powerful Candida cleanse.
A highly effective combination of protease (protein digestion), cellulase (cellulose digestion), and chitosanase (chitin digestion) enzymes can be found in Syntol. These enzymes deconstruct the Candida’s cellular structure and remove the organism’s shield of defence proteins.
Read more about Syntol and its Candida Cleanse benefits
Candida Symptoms
Although Candida can live inside the body without causing problems, candida can multiply if the environment changes, this can lead to infections and fungal growth. One common form of this infection is oral candidiasis, also known as thrush, which affects the mouth and throat. There are several signs that you may be experiencing candida overgrowth and will need to seek treatment. With the help of Syntol AMD – best probiotic for candida, you can start to restore the body’s natural balance and address candida overgrowth.
Although oral candidiasis can show on the body in various ways, the symptoms can range from mild to severe, including:
- White patches:
One of the main candida symptoms is white patches that appear in the cheeks, throat, tongue and roof of the mouth. They may look like cottage cheese and be painful
- Redness:
You will typically see redness and soreness in the affected areas. This symptom can make eating and drinking uncomfortable thus disrupting your daily life.
- Cotton-like Feeling In The Mouth:
Those with oral candidiasis often experience a feeling like they’ve got cotton in their mouth. This sensation can be distressing, affecting the mouth’s moisture balance and leading to difficulties in speaking and swallowing.
- Loss of taste
The presence of candida overgrowth can significantly impact the taste buds, leading to a temporary loss of taste. This can cause foods to taste bland which can impact your enjoyment of meals.
- Pain:
If left untreated, oral candidiasis can cause pain while eating or swallowing. This can cause those affected to avoid foods and drinks which can lead to lack of nutrition.
- Cracking At The Corner Of The Mouth
One of the candida symptoms is known as angular cheilitis, which involves the development of painful cracks in the corners of the mouth along with redness. This can make opening the mouth, eating and speaking challenging.
Syntol AMD is the best probiotic for candida and is designed to support the body’s natural digestive and immune systems, which can target candida overgrowth. By promoting a healthy balance of gut flora, Syntol AMD can help to ease the symptoms of oral candidiasis, restoring your comfort and well-being. If you’re experiencing any of the symptoms above, consider how Syntol AMD (best probiotic for candida) could help manage this overgrowth and help restore your health.
Causes Of Candida
Although candidiasis in the mouth is rare in healthy adults, there are certain factors that put those at risk of experiencing fungal overgrowth. If you experience any of these risks you may want to try taking a probiotic for candida to prevent this problem. Risks include:
- Dentures:
Those who have false teeth, especially if they are poorly fitted can create an environment for candida to thrive. If this is the case, you will need to maintain proper dental hygiene as well as taking regular trips to the dentist.
- Diabetes:
People living with diabetes are at higher risk of developing thrush. This is because of the higher blood sugar levels which is the ideal environment for candida to multiply.
- Immune system challenges:
Those with a compromised immune system whether that’s caused by HIV or cancer treatments are more susceptible for candida overgrowth and may benefit from taking a probiotic for candida.
- Smoking:
Smoking can alter the mouth’s environment making it more appealing to candida growth. Quitting smoking will eliminate this risk.
What Is Syntol?
You may be asking, what is Syntol AMD? Syntol is a combination of probiotics and prebiotics designed to promote a healthy balance of gut flora, as well as help the body maintain a balanced internal environment.
What Is Syntol Used For?
Syntol AMD is used to support digestive health as well as promote a healthy balance of gut bacteria. Containing a combination of probiotics and prebiotics that work together to reduce digestive problems such as bloating and gas; they improve digestion and overall gut health. Syntol AMD contains unique spore forming probiotics that are more likely to survive the digestive tract’s harsh environment. The enzymes in this supplement work to break down complex carbohydrates which are difficult to digest and makes the absorption of proteins and fats much easier. As an enzyme supplement, Syntol AMD is suitable for those with digestive problems or those looking to support their digestive health.
What Is Candida?
Candida is yeast found in the body, some strains of candida can cause fungal infections called candidiasis. If you have candida you may be prescribed antifungal medication.
What Are Probiotics?
Probiotics are live bacteria and yeasts found in your body. They are generally good for you and can help with digestion. Probiotic supplements, specifically a probiotic for candida, can help with digestive problems.
Is Syntol A Probiotic?
Yes, Syntol AMD is both a probiotic and prebiotic supplement that supports your digestive and immune health. The probiotics have the ability to survive the acidic environment in the stomach and therefore reach the intestines, where they work the best. The probiotics work simultaneously to balance the microbiome, support digestive health and boost the immune system. Syntol AMD also contains prebiotics that work together to support healthy digestion and improve nutrient absorption.
What Are The Signs You Need Prebiotics?
There can be many signs that your body is in need of prebiotics. If you’re experiencing digestive problems and have uncomfortable symptoms including: bloating, constipation, diarrhoea, gas and abdominal discomfort. If you have a weakened immune system you should also consider taking a prebiotic. If you have a history of using antibiotics, this can disrupt the balance of bacteria in your gut, so it’s necessary to take prebiotics to help bring health back to your gut.
If you suffer from mood disorders such as anxiety and depression, you may also benefit from taking prebiotics. By feeding the beneficial bacteria in the gut, which produce neurotransmitters such as serotonin and dopamine which play a crucial role in regulating your mood and emotions. It is known that around 90% of serotonin is produced in the gut, therefore it’s important to take care of our gut health in order to protect our mental wellbeing. By taking Syntol AMD you can support the growth of beneficial gut bacteria and improve your overall health and wellbeing.
How Long Does Syntol Take To Work?
The time that it takes for the Syntol AMD supplement to work varies from person to person. Depending on the severity of the gut issues, your overall health, and your diet and lifestyle. For those taking Syntol AMD for digestive issues, some people may experience relief from symptoms such as bloating and gas within a few days of taking the supplement, whereas others may take several weeks to fully notice an improvement in their gut health. Other factors will support the effectiveness of Syntol AMD such as a healthy diet and exercise. Although results will vary, many people report seeing significant improvements in their gut health and wellbeing after starting Syntol AMD over a course of several weeks or months.
Syntol Directions and Dosage:
Take Syntol with 8 oz of water on an empty stomach. Start with 1-2 capsules per day and increase by 1-2 capsules per day until you reach your desired amount. Larger daily doses may be split into 2-3 divided doses. For an aggressive Candida Cleanse 9 – 12 capsules a day can be taken. For a less aggressive treatment 6 capsules a day may be taken. For maintenance 2 – 4 capsules a day is sufficient. Syntol should always be taken on an empty stomach, well away from food. If taking Neprinol AFD, Syntol should be taken at the same time.
__________________________________________________________________________________________________________
Syntol/Vitacel/Neprinol AFD/Fibrovera/Serretia Testimonial Review: I have been using Neprinol, Fibrovera, Seretia, GH7 (continuously) and Syntol (as needed) for about six months now. I am a 51 year old woman, who has had the menopause and who has used to being mentally and physically very active through out my life. When I started using them I was feeling exhausted all the time, sluggish in my thinking, depressed about my lack of energy and having a hard time sleeping at night. The world felt decidedly grey.
I am a psychotherapist, and knew that these symptoms were not to do with anything going on in my life, but were more physically based. Because of years of dancing and horse riding, I also have arthritis in both hips and was looking for some relief from inflammation. Initially (after taking these supplements) I went through a period of detoxing, feeling achy and still tired, but I could tell that my body was detoxing….. (many visits to the bathroom!) I also started immediately to feel more alive.
However within a few weeks I started to notice that my mind was becoming increasingly clear and that my energy was returning. Now, though I am still aware that I am not 20…. (thank goodness)…… I feel positive, energised, clear thinking, and excited about life. The world has regained is colour! I have also found that I recover better from winter viruses and soft tissue injuries.
Sadly I have to say that I haven’t noticed much improvement in my arthritis, or my experience of inflammation, but to be fair, according to the x-rays that I have recently had done, the arthritis is advanced…. so that would be a bit of a miracle…! I also found the support service that the company provides is excellent.
I generally order by phone and receive very personal care and advice about dosage and a real interest in my on going experiences using these supplements. Honestly my quality of life is transformed. The pills are expensive, but you can cut the dose down over time. However I feel that it is more that worth it. Ros S. Pembrokeshire.
___________________________________________________________________________________________________________________________________________________
Syntol AMD (Advanced Microflora Delivery) supplement is not intended to treat, diagnose or cure any disease.

We hope that you are satisfied with the products you order from us. However, unused and unopened items in their original condition with seals intact may be returned within 14 days for a full refund or exchange, less any shipping charges. Please email info@advanced-supplements.co.uk to process a return quoting Order Number, Product to be returned and Reason for Returning.